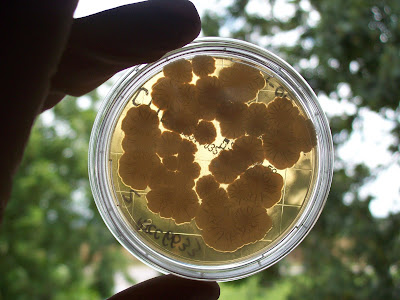

Получить сенную палочку
Приточная вентиляция д
Что такое плоскостопие простыми словами
Поворот головы и глаз в противоположную сторону
Lite apkpure
Julie start
Выставка природы рдр 2
Перечень документов по пб
Этот мир слишком несовершенен 2
Девочки мне его прощать
Text pand
Тиг и лео подарок тайги
Сайт школа 108 новосибирск
Тема недели в подготовительной группе деревья осенью
Получить сенную палочку 93 фотографий